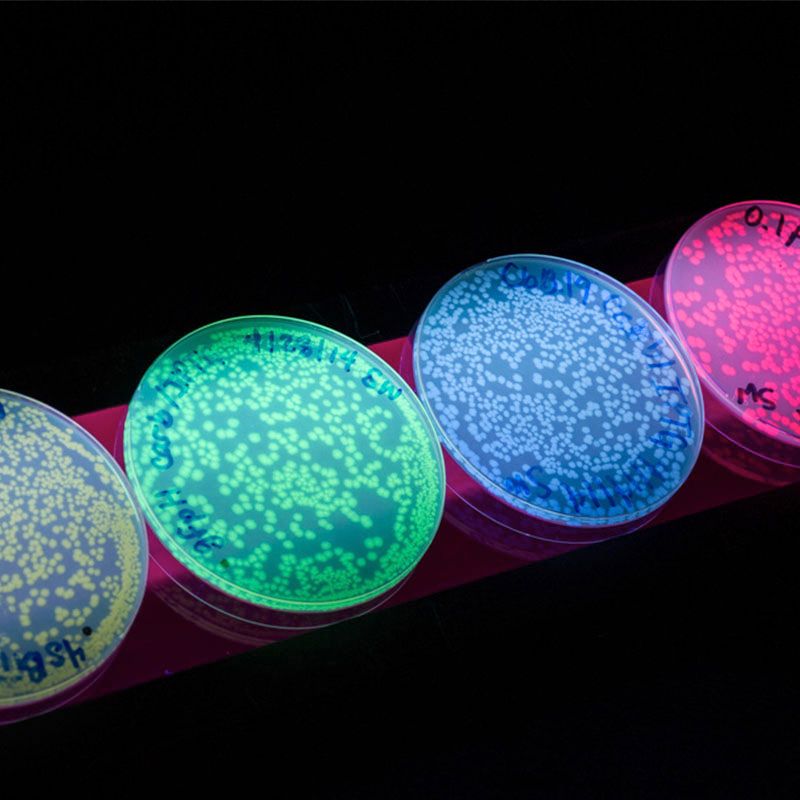
Petri dishes glowing in different fluorescent colors under UV light, each containing numerous small bacterial colonies.

Advanced Bioinformatics
The Advanced Bioinformatics Core uses sophisticated computational and statistical methods to analyze complex biological data, such as large-scale genomic, transcriptomic, and proteomic datasets, to gain deeper insights into diseases, drug discovery and fundamental biological processes.
Services
Our services include end-to-end project management, including conception, planning, and execution. Team members also deliver a series of hands-on instructional modules for workforce development and training in bioinformatics. Course content is delivered in small group settings via an active-learning instructional model; individualized expert consultation in bioinformatics is also available.
Location
Krone Engineered Biosystems Building (EBB) – Room 2200
Contact Us
Access to the core facilities is managed through the campus-wide Shared User Management System (SUMS). Get more information or become a user by visiting SUMS.
